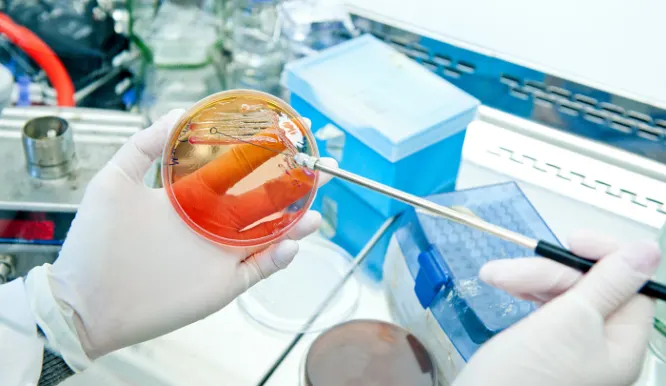
Phytochemical Analysis

Address
A2/104, Sangath Nano, Motera – Koteshwar Road, Koteshwar, Ahmedabad, Gujarat – 380005, India

Our advanced Biochemistry Laboratory is fully equipped to perform both qualitative and quantitative phytochemical analyses. We specialize in the detection and estimation of key biomolecules, including alkaloids, carbohydrates, phenols, tannins, saponins, terpenoids, and glycosides. The facility operates with flexibility to support diverse research and academic requirements, ensuring reliable and timely results.
We offer comprehensive antimicrobial activity testing to assess the ability of samples to inhibit the growth of microorganisms, including bacteria, fungi, and yeasts. Using standard methods such as agar well diffusion and disc diffusion, samples and controls are tested against selected strains from the ARF culture bank. For advanced analysis, the Minimum Inhibitory Concentration (MIC) can also be determined, identifying the lowest concentration of a sample that effectively prevents microbial growth.

ARF provides comprehensive soil testing services to assess fertility and overall soil health. Our laboratory is equipped with standard facilities for analyzing pH, nitrogen, phosphorus, potassium (NPK), and organic carbon levels, along with detailed microbial population studies.
